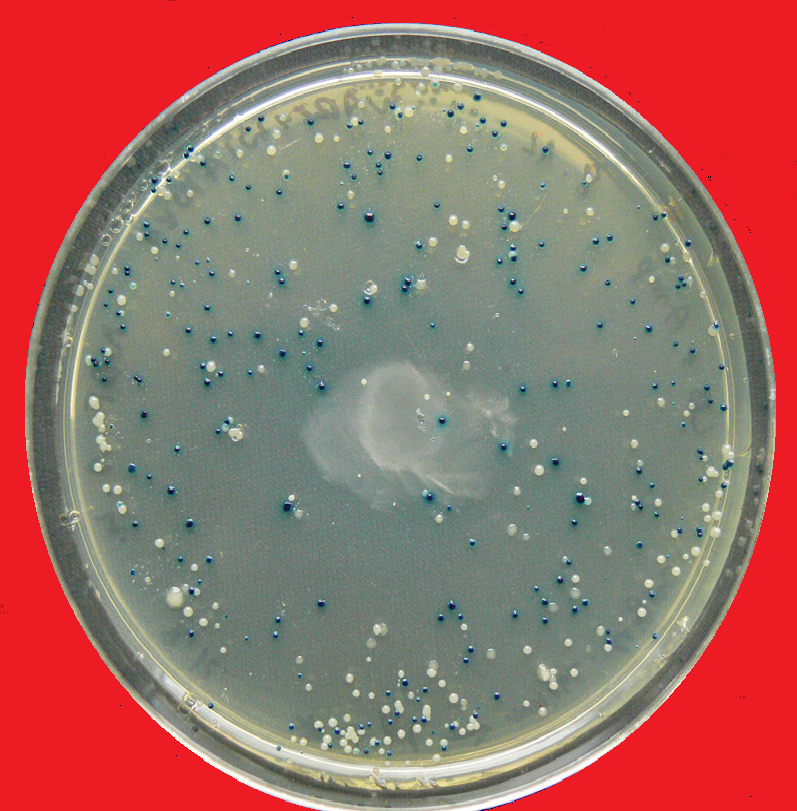
Happy Independence Day from MSBT! Enjoy the holiday! #red #whiteandbluescreen #USA #Merica #science #iGEM2015

UMICH SynthBio
@michigan_igem
The Michigan Synthetic Biology Team is a student run research group at the University of Michigan that participates in the annual iGEM competition/conference.
ID: 3344517351
https://www.facebook.com/MSBT2015 24-06-2015 20:45:11
16 Tweet
116 Followers
201 Following







5 days left! Help us get to Boston! Please spread the word on #aptapaper! #iGEM2015 experiment.com/projects/aptap… #forscience via Experiment

3 days left in our crowdfunding campaign! #aptapaper #science #iGEM2015 experiment.com/projects/aptap… #forscience via Experiment

93% funded! On our last day, help us make it to 100%! #aptapaper #iGEM2015 #science experiment.com/projects/aptap… #forscience via Experiment

16 hours left to donate! Thanks to everyone! #aptapaper #iGEM2015 #UMICH #science experiment.com/projects/aptap… #forscience via Experiment


Thanks so much for your support, Pietro Gatti! We appreciate it and look forward to bringing you updates on our progress!

Chatting with iGEM Bielefeld-CeBiTec 2024 about our projects! Looking forward to seeing each others progress! #iGEM2015 #science




Thanks David Boyer! Wish you were here! #iGEM2015 x.com/subletterdave/…